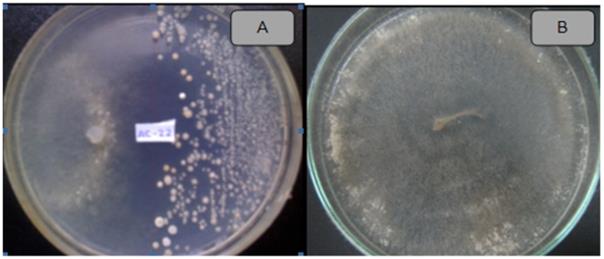
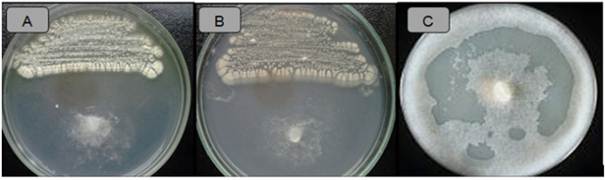

El control biológico o biocontrol utilizando microorganismos se ha convertido en una alternativa en el tratamiento de patógenos de plantas, siendo considerado como una de las prácticas más eficientes y ecológicamente sanas en el desarrollo de una agricultura sostenible (Franco-Correa, 2009). Los fitopatógenos originan grandes pérdidas económicas en la agricultura, al disminuir tanto la cantidad, como la calidad de los productos cosechados, y por lo tanto su valor comercial. El control de estos patógenos por lo general se ha realizado empleando plaguicidas y otros químicos, los cuales ha tenido efectos negativos sobre el ambiente y la calidad de vida de las poblaciones humanas (Serrano y Galindo, 2007). La aplicación sistemática de productos químicos en la agricultura implica actualmente dificultades como el resurgimiento de plagas, el desarrollo de resistencia genética de microorganismos, la contaminación del ambiente y daños a la salud humana (Pérez, 2004).
El interés en el biocontrol de patógenos de plantas se ha incrementado actualmente, particularmente como una respuesta a la preocupación de los consumidores frente al uso de los agroquími cos. Actualmente, el biocontrol ya es considerado como una de las prácticas de manejo de enfermedades de las plantas causadas principalmente por patógenos de los géneros Rhizoctonia, Sclerotium, Pythium, Phytophthora y Fusarium (Serrano y Galindo, 2007). En el control de dichos por patógenos, resulta importante la selección de potenciales antagonistas que pueden ser utilizados como controladores biológicos, para lo cual es necesario realizar inicialmente ensayos in vitro que generen una orientación respecto a su capacidad antagonista y permitan potencialmente ser formulados y utilizados posteriormente en campo (Gohel et al., 2006).
Entre los microorganismos útiles en el biocontrol de fitopatógenos se encuentran bacterias de los géneros Streptomyces, Pseudomonas, Agrobacterium y Bacillus (Whipps, 2001). Estos microorganismos se encuentran en suelos fértiles, siendo el grupo más prolífico los actinomicetos, bacterias Gram positivas, aerobias y principales degradadores de la materia orgánica en el suelo con capacidades de producir compuestos antimicrobianos, terpenoides, pigmentos y enzimas extracelulares (Ezziyyani et al., 2004). Representan entre 20 a 60 % de la población microbiana del suelo fértil, siendo sus principales actividades las de fijar nitrógeno, solubilizar fosfatos, promover el crecimiento de las plantas y producir una serie de metabolitos secundarios como vitaminas, enzimas y otros compuestos benéficos para las plantas (Bobadilla y Rincón, 2008). Adicionalmente, los actinomicetos ayudan a mejorar la fertilidad del suelo y a la vez producen compuestos bioactivos que permiten ejercer acción directa o indirecta como organismos de biocontrol de eventuales patógenos (Franco-Correa, 2008).
Los actinomicetos se caracterizan por producir metabolitos con actividad antimicrobiana, incluyendo biocontrol de fitopatógenos (Crawford et al., 1993; Park et al., 2002). Cepas de Streptomyces sp. han mostrado capacidad de suprimir el crecimiento de fitopatógenos in vitro, y por ello, muchos de sus metabolitos han sido propuestos para inhibir el crecimiento de estos patógenos in vivo (Franco-Correa, 2009). Enzimas extracelulares como quitinasas y β-1,3-glucanasas desempeñan una función significativa en la actividad antifúngica y biocontroladora, siendo responsables del micoparasitismo ejercido por ciertas cepas de Streptomyces y la supresión de enfermedades de las plantas (Goodfellow y Williams, 1983; Gonzáles et al., 2003).
La papa (Solanum tuberosum L.), es el cuarto cultivo más importante en el ámbito mundial, con una producción anual de 328, 865, 936 TM (FAO, 2008). En Perú, el cultivo de papa es el más importante en la zona andina, siendo la superficie cultivada de 249,000 ha. La producción de la papa en Perú se incrementó de 3,8 millones de TM en 2004 a 4,5 millones de TM en 2013, lo cual significó un crecimiento de 45% y una tasa promedio anual de 3,8% (INEI, 2014). Sin embargo, el cultivo de este tubérculo es afectado por varias enfermedades, siendo importantes las causadas por hongos y bacterias (Farfán y Gutiérrez, 2009). El "tizón tardío", causada por el Chromista Phytophthora infestans ha sido considerado como el principal patógeno a escala mundial (Arios, 2005). Rhizoctonia solani Kühn, causante de la rizoctoniasis o costra negra (por la formación de esclerocios) y chancro del tallo (por las lesiones necróticas en los tallos) es un patógeno fúngico presente en todas las zonas productoras de papa del mundo (Torres, 2002). Son varias las especies de Fusarium que se citan como responsables de la "pudrición seca". La bacteria Ralstonia solanacearum causante de "marchitez bacteriana" (Yabuuchi et al.; 1995) tiene gran impacto en el cultivo de la papa en climas fríos, aunque su temperatura óptima de crecimiento es de 28°C (He et al, 1983). Las bacterias Pectobacterium carotovorum subsp atrosepticum, P. carotovorum subsp. caratovorum (antes Erwinia carotovorum) y P. chrysanthemi, causan la "pudrición blanda" de los tubérculos de la papa tanto en el campo como en el almacén, así como la "pudrición de los tallos" o "pierna negra" en plantas en crecimiento (Elphinstone, 1987).
El compost es un abono orgánico altamente humificado, rico en nutrientes y fuente de una variedad de microorganismos aerobios, entre ellos los actinomicetos, que se desarrollan en respuesta a diferentes niveles de temperatura, humedad, oxígeno y pH (Arslan et al., 2008). Esta investigación busca seleccionar cepas de actinomicetos aislados del compost con potencial actividad inhibitoria de patógenos que afectan al cultivo de papa (Solanum tuberosum L) con posterior aplicación potencial como agentes de biocontrol en el campo.
Materiales y Métodos
Muestras de compost. Fueron recolectadas 10 muestras de compost (100 g de muestra como promedio) de las instalaciones del predio conocido como "Casa Blanca" (propiedad particular) ubicado a 47 km de Lima - Perú. La toma de muestras se realizó en condiciones de esterilidad y posteriormente dichas muestras fueron colocadas en envases de primer uso y con tapa hermética. Fueron transportadas al laboratorio de Ecología Microbiana, Universidad Nacional Mayor de San Marcos para su inmediato procesamiento.
Patógenos de Solanum tuberosum. Las cepas de patógenos fueron proporcionados por el Centro Internacional de la Papa (CIP), de Lima, Perú. Éstos incluyeron cultivos bacterianos de Ralstonia solanacearum (cepa 204 Biovar 2A aislada de Solanum tuberosum - Huambos - Cajamarca, Perú) y Pectobacterium carotovorum subsp. atrosepticum (aislado de Solanum tuberosum - Chiras - Comas, Perú); así como los hongos Rhizoctonia solani (aislado de Solanum tuberosum Huancayo, Perú), Fusarium sp., (aislado de Solanum tuberosum Huancayo, Perú) y el Chromista Phytophthora infestans (aislado de Solanum tuberosum L. var. canchan Serrana - Oxapampa, Perú).
Aislamiento de actinomicetos a partir del compost. Para el aislamiento de actinomicetos, las muestras de compost fueron diluidas al décimo en solución salina 0.85 % (p/v) hasta 10-6 y se sembró 0.1 mL de cada dilución por diseminación en Agar Czapeck- Dox pH 7.2 y Agar Almidón Caseína pH 7.2 (Gurung et al., 2009) suplementado en ambos casos con nistatina (Merck) (50µg.mL-1) y cicloheximida (Merck) (50 µg.mL-1). Los cultivos fueron incubados a 28°C por 15 d. Se colectaron las colonias de actinomicetos y se conservaron en refrigeración en viales conteniendo agar Czapeck - Dox más glicerina (20% v/v) según León et al. (2007).
Selección de actinomicetos con actividad antagonista a bacterias fitopatógenas. Se realizó mediante el método modificado de "segunda capa" (Dopazo et al., 1988). Los actinomicetos fueron sembrados como macrocolonias en Agar Czapeck Dox pH 7.2 e incubadas a 28 ºC por 7 d. Las bacterias fitopatógenas fueron reactivadas en caldo nutritivo + 1% de glucosa (p/v), pH 7.0, y posteriormente inoculadas (10 µL) (0,5 escala Mac Farland) a 3 mL de agar semisólido licuado y temperado a 50°C y luego agregado rápidamente sobre los cultivos de los actinomicetos. Los cultivos fueron incubados a sus respectivas temperaturas de crecimiento (R. solanacearum a 30 ºC por 48 h y P. carotovorum a 26ºC por 48 h), realizándose luego las evaluaciones del tamaño (en mm) de los halos de inhibición (diámetro). Se consideró como positivo un diámetro ≥ a 5 mm.
Selección de actinomicetos con actividad antagonista al cromista y hongos. Esta prueba se realizó mediante el método de co-cultivo señalado por Taechowisan et al., (2005). Rhizoctonia solani, y Fusarium sp, fueron reactivados y sembrados en agar papa dextrosa (APD) (Merck); mientras el oomiceto Phytophthora infestans en agar centeno, incubándose en todos los casos a 28 °C por 7 d. Los actinomicetos se sembraron en APD en un extremo de las placas. Los cultivos de patógenos se cortaron en trozos pequeños (0,5 cm de lado) y se colocaron al extremo opuesto del cultivo de cada actinomiceto. Se incubó por 4-5 d a 28 °C; luego se procedió a efectuar la evaluación de la medida de la distancia de crecimiento (mm) entre el actinomiceto y el fitopatógeno. Se consideró como positiva una distancia ≥ a 5 mm.
Análisis microscópico y macroscópico de actinomicetos seleccionados. Se realizó mediante microcultivos de actinomicetos previamente seleccionados por su mayor actividad antagonista. Se aplicó el método de "bloques de agar" según Holt et al., (1994) con incubación en cámara húmeda a 28 °C por 5-7 d. La observación de las características morfológicas de su estructura micelial y de esporulación se realizó utilizando un microscopio compuesto (Nikon) con el objetivo de inmersión (100X) en láminas portaobjeto preparadas con Azúl de Lactofenol (Merck). En la evaluación macroscópica se tuvo en cuenta características fenotípicas de las colonias, tales como color, forma, tamaño, elevación, textura y pigmento difusible de las mismas.
Obtención del extracto crudo del compuesto antimicrobiano. Se realizó según Pandey et al. (2004) modificada para actinomicetos de suelos. Actinomicetos seleccionados, se inocularon en matraces Erlenmeyer de 500 mL, con 150 mL del medio extracto de levadura más glucosa (Sultan et al., 2002). Los cultivos fueron incubados a 28 °C por 10 d en agitación constante de 250 rpm, y posteriormente centrifugados a 4000 rpm por 25 min. La recuperación de metabolitos antimicrobianos a partir del sobrenadante se realizó mediante extracción con acetato de etilo y diclorometano (Merck) en una proporción 1:1 (v/v) y agitado vigorosamente por 1 h (Liu et al., 1986). El extracto crudo fue concentrado y separado con ayuda de un evaporador rotatorio (BUCHI R- 3000) a 40 °C; luego el residuo fue pesado y reconstituido con dimetilsulfoxido (DMSO) al 10 % para su conservación y análisis posterior.
Determinación de la actividad antimicrobiana del extracto crudo. Volúmenes de 50 µL del extracto crudo recuperado y reconstituido (4 mg/mL), se colocó en pocillos (5 mm) practicados sobre el medio Agar Nutritivo + 1 % de glucosa, donde fue previamente sembrada la bacteria testigo fitopatógena. Los cultivos fueron incubados a 30 °C por 48 h (R. solanacearum) y a 26 °C por 48 h (P. carotovorum). En las pruebas frente a los hongos fitopatógenos el medio utilizado fue APD con incubación a 28 °C por 5 d. La actividad antimicrobiana en todos los casos se determinó por la medida del tamaño del halo de inhibición (mm de diámetro) según Pandey et al. (2004).
Concentración Mínima Inhibitoria (CMI) del extracto crudo. Se realizó según Caviedes et al. (2002) en microplacas de 96 pocillos (Pure Grade - Merck). Las pruebas se realizaron distribuyendo las diluciones de los extractos crudos de los actinomicetos seleccionados en el caldo nutritivo + 1% de glucosa a doble concentración para las bacterias y caldo extracto de levadura + glucosa a doble concentración para los hongos y el oomiceto P. infestans. La cepa fitopatógena agregada a cada pocillo fue de 20 µL. Se incubó por 48 h para las bacterias y 5 d para los hongos y el cromista. Al cabo de este tiempo, se agregó 50 µL de tetrazolium (Sigma) a todos los pocillos y se incubaron durante 24 h. Un cambio de color del amarillo al púrpura fue interpretado como crecimiento de bacterias.
Resultados y Discusión
Aislamiento de actinomicetos del compost. Se aislaron un total de 85 cepas de actinomicetos provenientes de pilas de compost del predio "Casa Blanca". De los aislados, 51 actinomicetos se recuperaron del agar Czapeck Dox (ACZ) y 34 del agar almidón caseína (AAC). Los aislados para estudios posteriores se codificaron de acuerdo a su crecimiento en el medio de aislamiento primario y el número de muestreo.
En el presente trabajo, el aislamiento primario de actinomicetos a partir del compost fue ligeramente mayor en ACZ en comparación al AAC (Cuadro 1). Estos resultados son similares a los obtenidos por Horna (1996), aunque cabe señalar que en este último caso el aislamiento se realizó a partir de sedimento marino, un sustrato totalmente diferente al del presente trabajo.
Cuadro 1 Actinomicetos aislados de pilas de compostaje en proceso final, en el predio "Casa Blanca", ubicado en Lurín, Lima, Perú.
Actinomicetos antagonistas a fitopatógenos de papa. De la totalidad de actinomicetos aislados (n=85), 65 (76.4 %) mostraron tener actividad antagonista al menos frente a un fitopatógeno en prueba y 20 (23.5 %) resultaron negativos. Asimismo, 20 (23.5 %) resultaron tener actividad en contra de Ralstonia solanacearum y 14 (16.4 %) frente a Pectobacterium carotovorum (Figura 1). El aislamiento con mayor actividad contra R. solanacearum fue la cepa ACZII-35 (32 mm de diámetro), en cambio contra P. carotovorum mostró mayor actividad la cepa AACI-5 (30 mm) (Cuadro 2). Asimismo, los actinomicetos del compost evaluados por su antagonismo frente a hongos indican que 22 cepas (25.8 %) tienen actividad contra Fusarium sp., 52 cepas (61.1 %) contra Rhizoctonia solani y 36 cepas (43.5 %) contra Phytophothora infestans (Figura 1). De los actinomicetos evaluados, 4 cepas (4.7 %) (ACZI-24, ACZII-34, ACZII-52, ACZIII-69) mostraron amplio espectro de actividad antagonista a los 5 fitopatógenos; 10 cepas a los 3 patógenos fúngicos y 12 cepas a las 2 bacterias patógenas (Cuadros 2 y 3 ; Figura 2). El 72.9 % de actinomicetos inhibieron por lo menos un patógeno fúngico, en contraste el 43.5 % lo hicieron al cromista y el 23.5 % inhibieron por lo menos una de las bacterias patógenas. Los aislamientos con mayor actividad de inhibición fueron ACZI-22 frente a R. solani (inhibición de 27 mm de distancia) (Figura 3); ACZII-84 y ACZIII-88 a Fusarium sp (18 mm de distancia) (Figura 4) y AACI-5 a P. infestans (22 mm de distancia) (Cuadro 3 y Figura 5). Prapagdee et al. (2008) aislaron 146 cepas de actinomicetos de rizosfera y los confrontaron con dos hongos fitopatógenos (Colletotrichum gloesporiodes y Sclerotium rolfsii), solo 10 aislamientos mostraron capa cidad antagonista a ambos patógenos; de manera similar, en el presente trabajo solo 10 aislados mostraron tal capacidad frente a los tres hongos fitopatógenos evaluados. Los actinomicetos de suelos han resultado ser excelentes antagonistas a fitopa tógenos. Así, Ningthoujam et al. (2009) evaluaron 33 cepas de actinomicetos de suelos, de los cuales 4 mostraron actividad frente a patógenos de cultivos de arroz como Curvularia oryzae, Pyricularia oryzae, Bipolaris oryzae y Fusarium oxysporum.
Cuadro 2 Tamaño de los halos de inhibición originados por actinomicetos aislados de compost frente a bacterias patógenas de Solanum tuberosum.

Actividad de inhibición: buena ≥25mm; intermedia <25 y >15mm; escasa ≤15mm; no actividad (-)
Cuadro 3 Cepas de actinomicetos del compost seleccionados por su mayor actividad antagonista a hongos fitopatógenos de Solanum tuberosum (zona de inhibición en mm).

Actividad de inhibición: Buena ≥20mm; intermedia ≤20mm >15mm; escasa <15mm; no actividad (-).
Figura 3 Actividad antifúngica del actinomiceto ACZI-22 frente a Rhizoctonia solani (A), control (B).

Figura 4 Actividad antagonista de actinomicetos frente a Fusarium sp. Cepa ACZIII-84 (A), cepa ACZIII-88 (B), control (C).
Figura 5 Actividad antagonista de actinomicetos frente a Phytophthora infestans. Cepa ACZIII-88 (A), cepa AACI-5 (B), control (C).
Por otro lado, Iznaga et al, (2004) reportaron que de 563 actinomicetos aislados de suelos cubanos, 286 mostraron actividad antifúngica a patógenas de plantas. En el presente trabajo, el 23.5 % de los aislados tuvieron actividad antagonista frente a R. solanacearum, porcentaje ligeramente menor a los resultados obtenidos por Bittencourt & Da Silva (1999), quienes evaluaron 190 actinomicetos aislados de suelo y rizoplano del cultivo de tomate frente a R. solanacearum, resultando 52 de ellos activos contra este patógeno. Toledo (2004), evaluó tres cepas de Bacillus sp, obtenidas de suelos, las cuales presentaron capacidad biocontroladora in vitro sobre el patógeno P. carotovorum. Así mismo, Reinozo et al. (2006) aislaron Bacillus sp. del suelo, y 7 cepas tuvieron efecto inhibitorio in vitro sobre P. carotovorum; si bien las bacterias del género Bacillus son generalmente usadas para el biocontrol de enfermedades de cultivos, también es importante resaltar que los actinomicetos juegan un papel muy importante en la colonización de los suelos. Oskay et al. (2004) evaluaron 50 actinomicetos de suelos frente a fitopatógenos, de los cuales 3 tuvieron actividad contra Pectobacterium amylovora, 5 contra Pseudomonas viridiflova, 4 contra Agrobacterium tumefaciens y 5 contra Clavibacter michiganensis. En el presente trabajo, 13 actinomicetos fueron antagonistas contra P. carotovorum, mostrando que las cepas aisladas del compost resultan tener mayor capacidad de inhibición. Estas cepas mostraron capacidad antibacteriana y antifúngica.
Respecto a Fusarium sp., el presente estudio revela que el 25.8 % de los aislados resultaron antagonistas a este hongo, porcentaje considerablemente mayor comparado con los estudios de Oskay (2009), quien evaluó la actividad antifúngica de Streptomyces aislados de suelos frente a fitopatógenos como Penicillium sp., Alternaria alternata y Fusarium oxysporum, siendo éste último ser menos sensible a la actividad antagonista del Streptomyces. De Boer et al. (1998) demostraron que 12 % de las bacterias quitinolíticas generaron inhibición frente a F. oxysporum, mientras que 56 % inhibió a F. culmorum. Por otro lado, Ikeda et al. (2000) evaluaron 4000 actinomicetos, de los cuales solo 27 % resultaron ser antagonistas contra Fusarium sp. De estas investigaciones se puede concluir que Fusarium sp, tiene una gran variación en términos de susceptibilidad frente a los compuestos activos de actinomicetos.
El antagonismo de actinomicetos a R. solani en este estudio estuvo representado por 61.2 % de los aislados. Kathiresan et al. (2005) evaluaron actinomicetos, aunque aislados de sedimento marino contra diferentes fitopatógenos, reportando entre otros que 31 % tuvieron efectividad contra R. solani. Este resultado es menor al registrado en este estudio, a pesar que los actinomicetos marinos son considerados como mayores productores de estos metabolitos. Por su parte, Farfán y Gutiérrez (2009) evaluaron el efecto antagonista de 13 actinomicetos del compost sobre Rhizoctonia sp. y Fusarium sp.; 3 de estos aislados resultaron tener los mayores porcentajes de inhibición de Rhizoctonia sp. y 5 de Fusarium sp.
Respecto al tamaño de las zonas de inhibición, en el presente estudio los actinomicetos llegaron a inhibir hasta 27 mm de distancia frente a R. solani. Rothrock y Gottlieb (1981) reportaron zonas de inhibición de hasta 15 mm, lo que nos indica que nuestras cepas presentan mayor capacidad de antagonismo a este fitopatógeno. Por otro lado, P. infestans fue inhibida por 43.5 % de las cepas de actinomicetos evaluadas en este estudio; este valor es menor comparado a los resultados de Valois et al. (1996) quienes reportaron que Phytophthora sp. fue inhibida por 72 % de los actinomicetos aislados de suelos.
En las pruebas de antagonismo en el presente estudio se utilizó con éxito el agar Czapeck (ACZ); sin embargo, Al-Zahrani (2007) quien evaluó la actividad antagonista de Streptomyces sp. frente a Bacillus subtilis, Staphylococcus aureus, Escherichia coli, Salmonella typhi, Candida albicans y hongos fitopatógenos como Fusarium oxysporum y Rhizoctonia solani reportó mejores resultados en los medios agar almidón caseína para bacterias y agar extracto de malta-levadura, agar Sabouraud dextrosa y agar avena para los hongos. Las pruebas de antagonismo frente a los hongos patógenos efectuadas en el presente estudio se realizaron en el medio APD, demostrando que este medio es adecuado para las evaluaciones efectuadas. Otros autores en pruebas similares también utilizaron APD, sugiriendo inclusive su uso porque consideran que intensifica la inhibición del patógeno (Ezziyyani et al. 2004; Farfán y Gutiérrez, 2009). El agar avena (recomendado para el crecimiento de Phytophthora infestans) también se utilizó con éxito en el presente trabajo, a diferencia de lo encontrado por Duque y Quintana (2008) en pruebas similares de actinomicetos frente a F. oxysporum no tuvieron los mismos resultados. Estos resultados nos indican que el modo de acción de los antagonistas puede variar según el patógeno testigo. El antagonismo no solo varía entre hongos de diferente género como es el caso de este estudio, sino también entre hongos del mismo género pero diferentes especies; por mencionar el caso de De Boer et al. (1998) quienes reportaron que 12 % de las bacterias quitinolíticas antagonistas inhibieron el crecimiento de F. oxysporum, mientras que 56 % inhibió el crecimiento de F. culmorum.
Análisis macroscópico y microscópico de cepas seleccionadas. En la evaluación macroscópica y microscópica se tuvo en cuenta sólo a los actinomicetos que mostraron mayor antagonismo tanto a las bacterias como a los hongos fitopatógenos. Los actinomicetos seleccionados fueron las cepas ACZII-35 y AACI-5 (por ser mejores antagonistas a R. solanacearum y P. carotovorum, respectivamente) y las cepas ACZI-22, ACZIII-88 y ACZIII-84 (por ser mejores antagonistas contra R. solani, Fusarium sp. y P. infestans respectivamente). Los resultados se pueden observar en la Cuadro 4. Las características de cultivo y las observaciones microscópicas a partir de microcultivos y el comportamiento cultural de las 5 cepas de actinomicetos seleccionados nos indican que todos son posibles miembros del género Streptomyces (Figura 6), sin embargo se debe confirmar mediante pruebas moleculares.
Cuadro 4 Características fenotípicas de actinomicetos seleccionados por su mayor actividad inhibitoria de fitopatógenos de Solanum tuberosum.

Figura 6 Observación microscópica de los actinomicetos seleccionados por su mayor actividad antimicrobiana frente a fitopatógenos de S. tuberosum. Cepas AACI-5 (A); ACZI-22 (B); ACZII-35 (C); ACZIII-84 (D) y ACZIII-88 (E). Aumento: 1000X.
Según la literatura consultada, el género Streptomyces es el principal responsable en la producción de la mayoría de los metabolitos bioactivos. En particular, Streptomyces forma parte de un grupo importante dentro de los actinomicetos, porque éstos son capaces de producir varios tipos de metabolitos secundarios (Baltz, 2006).
Pero no solo Streptomyces habita en el suelo, incluido el compost; también otros géneros de actinomicetos como lo reportaron Remya y Vijayakumar (2008); quienes de 64 colonias de actinomicetos, identificaron Streptomyces (30) (47%), Glicomyces (10), Nocardiopsis (7), Nocardiodes (4), Actinopolispora (3), Nocardia (3), Kibdelosporangium (2), Actinosinnema (1), Kineosporia (1) y Saccharopolyspora (1). De igual manera, Nakashima et al. (2009) aislaron 800 cepas de actinomicetos, los cuales fueron comparados con cepas de NBRC (National Biological Reserch Center), 64 de ellas mostraron similitud con 36 Streptomyces NRBC, específicamente al grupo Streptomyces griseus, con actividad frente a Kocuria rhizophila y Aspergillus oryzae; además productoras de compuestos como streptomicina y bafilomicina con actividad antibacteriana y antifúngica, respectivamente. Yuan y Crawford (1995) señalaron mecanismos de Streptomyces lydicus WYEC108 (aislado de la rizósfera de plantas) en el control de Pythium ultimum a través de antifúngicos y quitinasa extracelular que destruye no solo las esporas, también dañan la pared celular de las hifas, demostrando que S. lydicus WYEC108 tiene potencial biocontrolador sobre P. ultimum.
Obtención del extracto crudo y actividad antimicrobiana. Los extractos obtenidos después del cultivo y posterior obtención con solventes orgánicos fueron concentrados hasta obtener los pesos secos de cada cepa (Cuadro 5). La extracción de compuestos activos se realizó utilizando dos solventes de polaridad distinta como son el diclorometano (DCM) y el acetato de etilo (EtAC). Se observó ligera variación en la recuperación de extractos crudos; en este caso los extractos de EtAC mostraron cierta ventaja a los del DCM. Asimismo, en cuanto al rendimiento antimicrobiano, el extracto recuperado con EtAC tuvo mejor actividad inhibitoria que el de DCM. Leiva et al. (2004) seleccionaron 13 cepas de un total 31 actinomicetos para obtener extractos con 5 solventes de polaridad creciente; éstos fueron éter de petróleo, cloroformo, etilmetilcetona, acetato de etilo y butanol; siendo los extractos más activos los obtenidos con etilmetilcetona y acetato de etilo. Asimismo, Remya y Vijayakumar (2008) utilizaron extractos obtenidos con acetato de etilo, metanol, cloroformo y etanol frente a Staphylococcus aureus, Bacillus subtilis, Escherichia coli, Salmonella typhi, Cryptococcus neoformans y Candida albicans; siendo el extracto de acetato de etilo el de mayor capacidad de inhibición. Otros autores como Dhanasekaran et al. (2005), obtuvieron resultados distintos a partir de extractos con anilina, cloroformo, piridina y acetato de etilo frente a E. coli, K. pneumoniae, Ps. aeruginosa, V. cholerae, S. typhi, Sh. disentirae, S. aureus, P. mirabilis y B. subtilis; sin embargo, los extractos de acetato de etilo fueron los que generaron mejores resultados. Narayana et al. (2008) separaron 4 fracciones bioactivas del extracto crudo de acetato de etilo de Streptomyces sp. y los enfrentó a hongos fitopatógenos, resultando Fusarium udum y Penicillium citrinum susceptible a las 4 fracciones, mientras Fusarium oxysporum mostró resistencia a una de las fracciones. En este sentido, nuestros resultados ratifican al EtAC como uno de los mejores solventes en la recuperación de metabolitos bioactivos de actinomicetos. La actividad antimicrobiana de los extractos crudos obtenidos con los dos solventes fue evidente tanto para las bacterias como los hongos patógenos de la papa. Algunos resultados de estas pruebas se pueden observar en la Figura 7. Respecto a la actividad antimicrobiana de los actinomicetos existen diversos trabajos que señalan su producción durante la fase exponencial final y la estacionaria. Prapagdee et al. (2008) aislaron S. hygroscopicus productor de un potente inhibidor de fitopatógenos; estos productos fueron una quiti nasa extracelular y una β-1,3-glucanasa producida durante la fase exponencial y exponencial tardía respectivamente. Según Joo (2005), Streptomyces halstedii AJ-7 produce una quitinasa celular, la cual causa en las hifas de los hongos morfologías anormales, aberraciones en su crecimiento, hinchazón de las hifas y lisis de la pared celular. Farfán y Gutiérrez (2009) señalan que es posible que exista sinergismo en el proceso de inhibición de los hongos fitopatógenos entre enzimas tipo quitinasas y otros metabolitos antifúngicos.

Figura 7 Actividad inhibitoria del extracto obtenido con Acetato de Etilo a partir de la cepa ACZIII-88 frente a Fusarium sp, (A) y de la cepa ACZII-35 frente a Pectobacterium carotovorum (B).
Concentración Mínima Inhibitoria (CMI) de extractos de actinomicetos frente a fitopatógenos. Los resultados de esta prueba se observan en la Cuadro 6. Se utilizaron los extractos de AACI-5 y ACZII-35 para determinar la CMI de P. carotovorum y R. solanacearum. La concentración inicial para los extractos de EtAC y DCM fue de 2 mg.mL-1. En términos generales, se puede afirmar que el extracto DCM de la cepa ACZII-35 tuvo mejor rendimiento, alcanzando una CMI de 0.125 mg.mL-1 frente R. solanacearum; en tanto que para P. carotovorum fue el extracto EtAC de la cepa AACI-5 que alcanzó una CMI de 0.2 mg.mL-1. Para determinar la CMI de Fusarium sp. se eligió los extractos de las cepas ACZIII-84 y ACZIII-88, siendo la concentración inicial de 2 mg.mL-1. El rendimiento de ambos extractos fue bajo (Cuadro 6). En el caso de la CMI de R. solani se utilizaron los extractos de ACZI-22 y ACZIII-88 con una concentración inicial de 2 mg.mL-1. Los resultados señalan que para inhibir a este patógeno fue necesario 0.125 mg.mL-1 del extracto DCM de la cepa ACZIII-88. Los otros extractos alcanzaron resultados bajos. Finalmente, los extractos de AACI-5 y ACZIII-88 se utilizaron para determinar la CMI de P. infestans; siendo la concentración inicial para ambos extractos de 4 mg.mL-1. En este caso los extractos mostraron buen rendimiento a concentraciones bastante bajas, siendo suficiente 0.0625 mg.mL-1 (62.5 µg.mL-1) del extracto EtCA de la cepa AACI-5 para inhibir el desarrollo del oomiceto P. infestans. Trabajos similares al presente fueron realizados por Narayana et al. (2008), quienes determinaron la CMI de 4 fracciones del compuesto bioactivo de Streptomyces sp. ANU 6277 frente a F. udum, Penicillium citrinum y F. oxysporum, resultando susceptibles a la fracción AF3 a concentraciones de 2, 5 y 10 µg.mL-1 respectivamente. Taechowisan et al. (2005) determinaron la CMI de dos fracciones (i) y (ii) del compuesto bioactivo de Streptomyces aureofaciens CMUAc 130 frente a Colletotrichum musae, siendo estos valores de 120 y 150 µg.mL-1 respectivamente.
Cuadro 6 Concentración Mínima Inhibitoria (mg.ml-1) de extractos crudos de actinomicetos.

Extractos: EtAC (Acetato de Etilo); DCM (Diclorometano); (-) Negativo; ND: no determinado
Si bien, en este trabajo la CMI se evaluó a partir del extracto crudo que contenía el compuesto bioactivo, otros autores como Taechowisan et al. (2005) y Narayana et al. (2008), evaluaron la CMI a partir de fracciones purificadas, por lo tanto la actividad inhibitoria fue más eficiente. Los ensayos in vitro son preliminares para saber si los microorganismos son buenos antagonistas y de esta manera evaluar su posible uso en ensayos in vivo, tal como plantearon Bittencourt et al. (1998), quienes evaluaron 190 actinomicetos aislados de rizosfera de tomate frente a Ralstonia solanacearum, de los cuales 18 mostraron 100% de efectividad, siendo la mejor vía de inoculación en semillas o raíces. Tuomi et al. (2001) aplicaron a través de un sistema de irrigación para el control de patógenos importantes como F. oxysporum, Botritis cinerea y Alternaria brassicicola.
Conclusión
Este estudio demuestra que cepas de actinomicetos aislados de compost poseen un relevante antagonismo contra importante fitopatógenos fúngicos y bacterianos de Solanum tuberosum spp. andigena. Esto permite afirmar que representan posibles candidatos para ser utilizados en programas de control biológico, en la producción de dicho cultivo, como parte de una práctica de agricultura sostenible.










texto en 





